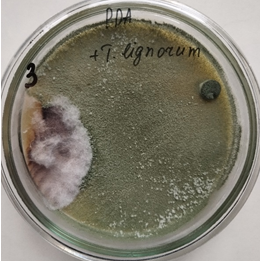
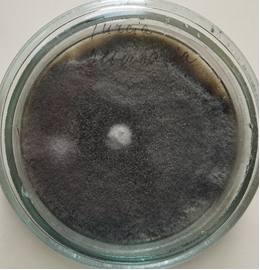

TRICHODERMINĂ, SC
TRICHODERMINĂ, SC
Trichodermin, SC-
Designation: contact fungicide used for grain, industrial,
legume and vegetable seed treatment against the pathogens causing root rot,
treatment of grapevines for suppression of grey rot. The fungus Trichoderma lignorum suppresses the
development of Alternaria spp., Fusarium spp., Rhizoctonia solani, Thielaviopsis
basicola, Helminthosporium spp.
and some other pathogens that damage agricultural and ornamental plants.
Producer: Institute of Genetics, Physiology, and Plant
Protection, Moldova State University, Laboratory of Phytopathology and
Biotechnology, str. Pădurii, 20, Chişinău, MD – 2002, Moldova, Tel.
(+37322) 770447, Fax: (+37322) 556180,
E-mail: institut.gfpp@gmail.com
The strain is deposited in the
National Collection of Non-Pathogenic Microorganisms under registration number Trichoderma lignorum CNMN-FD-14.
The biopreparation is included
in the State Register of Phytosanitary Protection Products of the Republic of
Moldova in 2015 year, with re-registration in 2022 year, under the number
22-09-06-08-2-1143.
Preparation form: cultural liquid, brown-green color,
containing mycelium, spores, and biologically active substances produced by microorganisms
during cultivation.
Active substance: antagonistic fungus Trichoderma lignorum M-10, Titre 108
CFU/ml.
Solvent: water.
The risks of using: The product is non-toxic and non-flammable.
The microorganisms may cause sensitive reactions when inhaled. It is not necessary to classify and label it
as a product that is harmful for the environment.
Method of application:
1. Wet processing of seeds
before sowing – 0.5 liters of preparation per 10 liters of water per 1 (one
ton) of seeds.
2. Treatment of grapevines and
fruit trees during vegetation against gray rot - 10 l/ha, 500 l water. First
treatment immediately after flowering, subsequent treatments every 10–15 days,
depending on the development of the disease and weather conditions.
The preparation is dissolved in water according to the
application recommendations.
In field conditions, the treatments are
carried out in the evening to avoid the negative effect of sunlight.
The water used to prepare the
solution must not contain any petroleum product residues.
The preparation takes effect
36–48 hours after application.
The optimum temperature for cultivation is +24…+28 °C, the maximum
temperature is +31…+33 °C, and the minimum temperature is +12…+18 °C.
Safety precautions: when applying the
preparation: Compliance with standard sanitary conditions. Mandatory use of
personal protective equipment; drinking water and smoking are not recommended
during application of the preparation. Avoid contact with skin and contact with
eyes. Clean the equipment, materials, and personal protective equipment
thoroughly after finishing work, and wash your hands thoroughly. Do not allow
the product to enter the sewage system.
Warning! When working with Trichodermina, SC, wear personal protective equipment, goggles, a
respirator, and gloves. If the product gets inside the organism, drink 1-3
glasses of water; if it gets into the eyes or on the skin, wash thoroughly with
water.
Scope of application: plants cultivation.
Phytotoxicity: absent. Plant and animal
protection is not necessary.
Transportation: The product can be
transported in the closed transport, protected from rain, at a temperature of +1….+28°C.
It is not recommended to transport the preparation together with food products.
Storage conditions: Store in an airtight
container at a temperature of +1...+4°C, away from food products. Keep away
from animals, unauthorized persons, and children. Before opening, mix well and
use within 2–3 days.
Guaranteed shelf life: One month, maintaining sterility at a temperature of +1...+4°C.

Germination of pea seeds on an agar medium, with a block of the pathogen Rhizoctonia solani in the center of the Petri dish.
1 – control, untreated seeds;
2
– seeds treated with a 5.0% aqueous suspension of the biopreparation
Trichodermina,SC.

Germination of pea seeds on an agar medium, with a block of the pathogen Fusarium sporotrichioides in the center of the Petri dish.
1 – control, untreated seeds;
2 – seeds treated with a 5.0% aqueous suspension of the biopreparation Trichodermina,SC.

Germination of pea seeds on an agar medium, with a block of the pathogen Sclerotinia sclerotiorum in the center of the Petri dish.
1 – control, untreated seeds;
2 – seeds treated with a 5.0% aqueous suspension of the biopreparation Trichodermina,SC.
As part of the project, the biopreparation was tested against pathogens isolated from the affected walnut tissues: Phoma juglandis, Fhyllosticta juglandis, Microstroma juglandis, Alternaria sp., and others
|
|
|
|
Phoma juglandis (fungus №3) – pure culture |
Phoma juglandis +T. lignorum – pathogen growth suppression |
|
|
|
|
|
|
|
Alternaria sp. |
Alternaria sp., + T. lignorum – i pathogen growth suppression |
As part of the project, the biopreparation was tested against pathogens isolated from the affected walnut tissues: Phoma juglandis, Fhyllosticta juglandis, Microstroma juglandis, Alternaria sp., and others.
|
|
|
|
Phoma juglandis (fungus №3) – pure culture |
Phoma juglandis +T. lignorum – pathogen growth suppression |
|
|
|
|
|
|
|
Alternaria sp.- pure culture |
Alternaria sp., + T. lignorum – pathogen growth suppression |